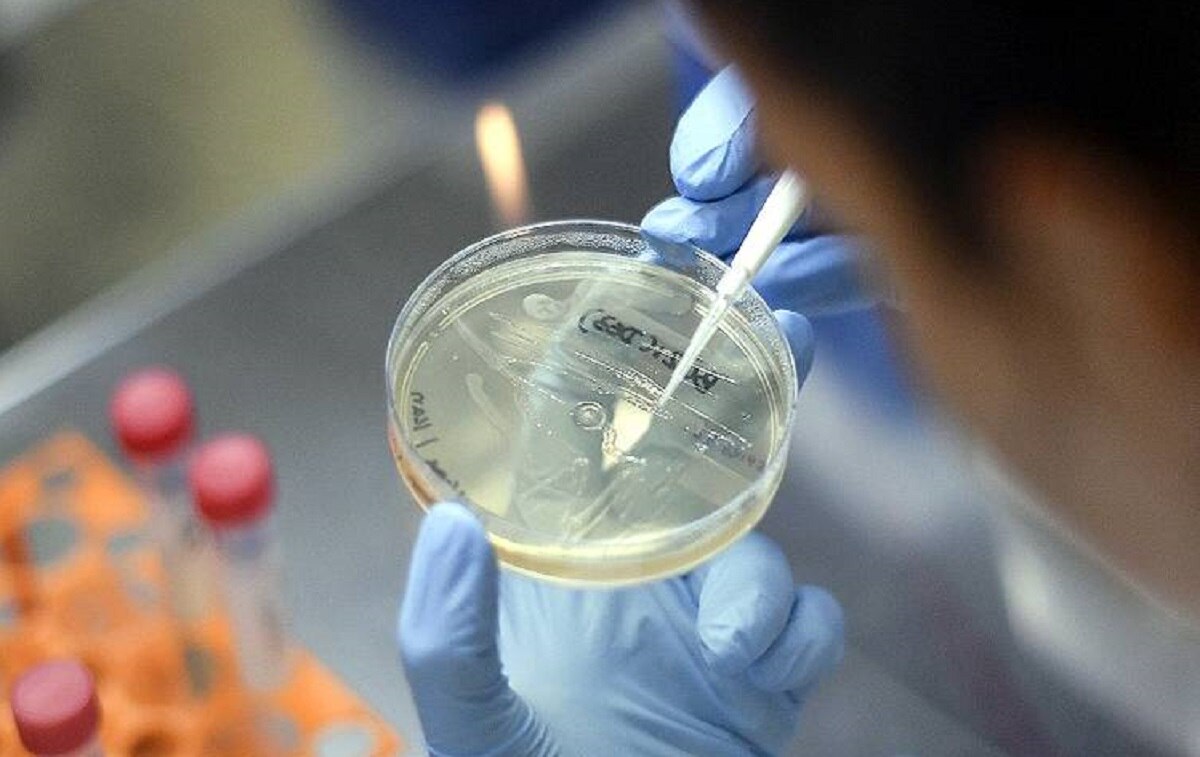
कोरोना का नया रूप

ब्रिटेन में कोरोना का नया रूप, ज्यादा तेजी से फैल रहा वायरस
दुनियाभर में वैक्सीन की चर्चा के बीच भी कोरोना का कहर कई देशों में जारी है. इसी बीच ब्रिटेन से एक डरावनी खबर सामने आई है. यहां कोरोना वायरस के एक नए प्रकार की पहचान की गई है, जो ब्रिटेन के दक्षिण-पूर्व इलाकों में काफी तेजी से फैल रहा है. (File Photos)
दरअसल, एजेंसी की रिपोर्ट के मुताबिक, ब्रिटेन के स्वास्थ्य सचिव मैट हैंकॉक ने कहा है कि देश में कोरोना वायरस के एक नए प्रकार की पहचान की गई है, जो ब्रिटेन के दक्षिण पूर्व इलाकों में काफी तेजी से फैल रहा है. उन्होंने हाउस ऑफ कॉमन्स में कहा कि कोरोना वायरस के नए प्रकार के अब तक 1000 से ज्यादा मामले सामने आ चुके हैं.
मैट हैंकॉक ने बताया कि यह वर्तमान में मौजूद कोरोना वायरस स्ट्रेन के मुकाबले काफी तेजी से फैल रहा है. हालांकि, उन्होंने कहा कि फिलहाल हमारे पास ऐसे कोई सबूत नहीं हैं कि कोरोना वायरस के इस नए प्रकार पर वैक्सीन का कोई प्रभाव नहीं पड़ेगा. इसका पहला मामला पिछले सप्ताह केंट में सामने आया था.
ब्रिटेन के मुख्य चिकित्सा अधिकारी ने भी शनिवार को पुष्टि की कि देश में सामने आया एक नया कोरोना वायरस तेजी से फैल सकता है. ब्रिटेन ने इस संबंध में विश्व स्वास्थ्य संगठन को जानकारी दे दी है. ब्रिटेन के वैज्ञानिक यह भी पता लगाने का प्रयास कर रहे हैं कि हाल में ही कोरोना मरीजों में वृद्धि कहीं इसी नए प्रकार के वायरस से तो नहीं हुई है.
उधर ब्रिटेन के प्रधानमंत्री बोरिस जॉनसन ने लंदन समेत कुछ और जगहों पर चौथे चरण के कड़े प्रतिबंध लागू करने की घोषणा की है. बोरिस जॉनसन ने स्पष्ट किया कि देश में त्योहार का मौसम इस बार पहले से अलग होगा. उन्होंने कहा कि पहले जो योजना तैयार की गई थी उसके अनुसार इस बार हम क्रिसमस नहीं मना सकते हैं. (File Photo)